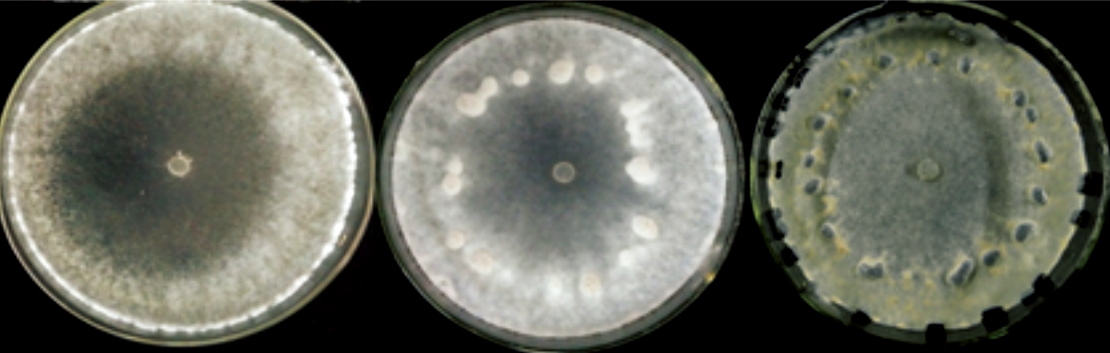
p>大白菜菌核病是由核盘菌引起的,发生在 a target="_blank" href="
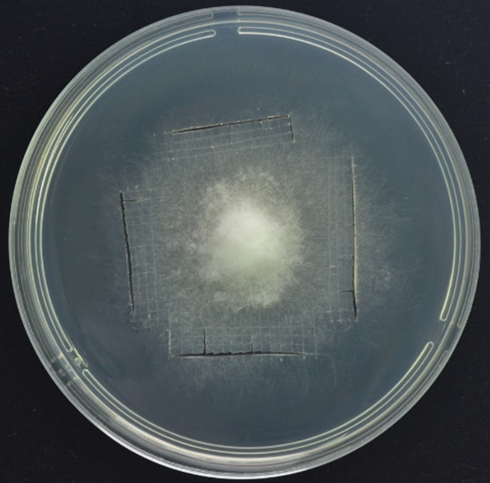
实验方案系列 | 核盘菌遗传转化系统的建立 - 知乎

核盘菌

核盘菌(菌核病病菌)
图片尺寸2592x1728
p>大白菜菌核病是由核盘菌引起的,发生在 a target="_blank" href="
图片尺寸1110x353
核盘菌
图片尺寸1012x768
这张图片显示的是核盘菌孢子爆裂出来的瞬间.
图片尺寸700x613
美澳型核果链核盘菌
图片尺寸640x298
p>核盘菌(sclerotinia sclerotiorum)是一种危害作物和蔬菜的世界性
图片尺寸442x707
核盘菌
图片尺寸1024x740
p>核盘菌属,菌核由黑色的外层和白色的髓部组成,不含寄主组织残余物
图片尺寸433x364
p>核盘菌属,菌核由黑色的外层和白色的髓部组成,不含寄主组织残余物
图片尺寸499x601
小晴说病害芹菜菌核病
图片尺寸581x454
核盘菌
图片尺寸685x678
p>核盘菌(sclerotinia sclerotiorum)是一种危害作物和蔬菜的世界性
图片尺寸1600x2744
核盘菌(菌核病病菌)
图片尺寸2592x1728
实验方案系列 | 核盘菌遗传转化系统的建立 - 知乎
图片尺寸490x483
p>小核盘菌,属于蜡钉菌目,核盘科,拉丁名是sclerotinia minor. /p>
图片尺寸800x575
核盘菌(菌核病病菌)
图片尺寸1728x2592
p>核盘菌(sclerotinia sclerotiorum)是一种危害作物和蔬菜的世界性
图片尺寸442x707
p>黄瓜菌核病是由 a target="_blank" href="/item/核盘菌/1496363"
图片尺寸601x400
p>核盘菌属,菌核由黑色的外层和白色的髓部组成,不含寄主组织残余物
图片尺寸503x603
对油菜核盘菌具强致病力的淡紫紫孢菌及其应用制造技术
图片尺寸993x1000